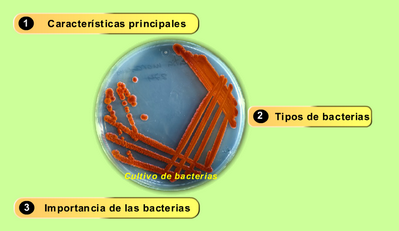

Uno entre un millón. Ese es Javier Fernández. Excepcional, grande, grandísimo, un extraterrestre y estratosférico patinador.
Con su mejor marca personal, y eso que partía de la segunda posición por una caída en el programa corto, se ha hecho, de nuevo, con el título mundial.
¡¡¡Felicidades!!!
Disfruta y sorpréndete, nunca has visto nada igual en el patinaje sobre hielo.
El Langui y el himno oficial para los Juegos Paraolímpicos
8 marzo – Día Internacional de la Mujer Trabajadora
Hoy, 8 de marzo, se festeja el Día Internacional de la Mujer Trabajadora, en memoria de la masacre ocurrida en 1908, cuando el propietario de una fabrica textil decidió que la mejor manera de sofocar la revuelta producida por las obreras en reclamo por mejoras laborales, era incendiarla con todas ellas adentro.
En España, el primer 8 de marzo se celebró en 1977, una fiesta que el movimiento de mujeres aprovechó para plantear sus problemas en el campo laboral. Un año más tarde, en 1978, la Constitución Española reconoció la igualdad ante la ley entre hombres y mujeres, cono uno de los principios del ordenamiento jurídico. Su posterior desarrollo normativo ha supuesto la equiparación de nuestro país, en cuanto a la igualdad de derechos entre los sexos, con el entorno europeo.
Para visitar:
Para festejar:
Para ver…
Ahora que estamos trabajando en Valores cívicos y sociales temáticas como la coeducación, la identidad de género o el respeto por las diferencias, nada como este sencillo pero espectacular anuncio comercial que pone en las manos de un chico bailarín un producto de limpieza.
No te pierdas el making of. La publicidad resulta muchas veces engañosa, como podrás apreciar.
Y si aún te quedan ganas de ver más de este talentoso y genial bailarín llamado Daniel Cloud Campos ofreciéndonos su particular y positiva visión de la vida…
Impresionante, Lady Gaga
Así de maravillosamente bien canta Lady Gaga el himno de los Estados Unidos al comienzo del partido de la Super Bowl 2016. Grandísima voz, mucho sentimiento y, sobre todo, patriotismo. ¡Cualquiera no se emociona con tamaña actuación!
Días de fiesta, sí, pero…
Cuatro días por delante de fiesta, de disfraces y máscaras. Cuatro días de felicidad y descanso, con la familia, aunque no siempre todos pueden disfrutarlo. Una charanga brinda un sentido homenaje a un pequeño… nosotros, maestros ante todo, nos unimos a él.
Solo vine a avisarle que mi hijo del alma
ya no vendrá jamás a estudiar a este centro,
anoche descubrimos abierta su ventana
pero él ya había volado de su habitación.
A los pies de un muñeco guardó en un cuaderno
esta carta de amor, esta derrota;
voy a robarle un mísero momento
quiero que la lea y después le ponga nota.
Leálo y dígame por qué estaba tan triste.
Léalo y dígame por qué quiso matarse.
Dígame que no es cierto lo que él mismo dice.
Leálo y dígame qué pasaba en las clases.
Tenía once años y ha saltao al vacío,/
la ciencia de la vida para los restos hemos suspendío.
Era un chiquillo bueno y brillante
y por lo visto acosao y humillao por cuatro cobardes.
Donde hay un lobo hay un cordero,
tras un rarito hay un matón y un padre que da miedo.
Usted no puede, usted no sabe,
usted tiene la llave pa que no ocurra más.
En memoria de Diego, sólo tenía 11 años. ¡Algo no estamos haciendo bien!
Los climas de España
Las interjecciones
Las interjecciones son palabras que expresan sentimientos muy vivos, de dolor, de alegría, de tristeza, etc. Podemos decir que son reacciones del hablante que se materializan a través de la palabra.
Estas palabras van siempre entre signos de exclamación.
oh!, ;ay!, ;ah!, ;bah!, ;uf!, ;zas!, ;hala!, etc.
 |
| Fuente de las imágenes: http://conlaclaseacuestas.blogspot.com.es/2014/11/basico-2-martes-11-de-noviembre.html |
Aunque se trata de una palabra, la interjección se comporta como una oración independiente, es decir, comunica un significado completo. Así, ¡ay! , tiene una significación plena, equivale a una oración. como: ¡me he hecho daño!
Observa las siguientes oraciones y el uso de las interjecciones en ellas:
¡Ay! ¡Qué dolor de pies tengo!
¡Atención! ¡Peligro!
¡Socorro! ¡Se ahoga un anciano!
¡Bravo! ¡Este bailarín es genial!
¡Oh! ¡Qué susto me ha dado usted!
¡Bah! ¿Tendrá todavía un millón de dólares a salvo!
¡Ah! ¡Entonces es cierto el rumor!
¡Viva!
¡Dios mío! ¡Qué suerte hemos tenido!
¡Olé! ¡Ese es mi chico!
¡Caramba! ¡Hay pasteles!
¡Anda! ¿Qué haces aquí?
Practica:
Aprende:
El cazo de Lorenzo
Maravilloso libro, con palabras sencillas y excelente ilustración, que gustará a niños y mayores (desde los 6 años). Tierno y divertido cuenta el día a día de un niño diferente: sus miedos y dificultades, los obstáculos que tiene que salvar… pero también sus cualidades, su enorme potencial.
Lorenzo es el personaje del cuento de Isabelle Carrier, un niño pequeño como los demás niños de su edad pero que tiene una peculiaridad que lo hace diferente a los demás: arrastra un cazo que le impide hacer algunas cosas o que le dificulta para otras. Pero se encontrará con una persona, también muy especial, que le ayudará a vivir con esa diferencia que los otros no entienden y que le hará ver que esa diferencia puede ser fuente de creatividad, de autoestima y de autoconfianza si cree en sí mismo y obtiene de ella todas sus capacidades. Capacidades que le harán sentirse feliz y que permitirá que todos los que le rodean le reconozcan.
El cazo de Lorenzo es una sencilla metáfora que nos habla de la diferencia y de la diversidad, de una diferencia y diversidad que enriquece y que no discrimina: todos somos diferentes y todos somos iguales.
Desarrollo de la actividad
Presentación del libro. Antes de la lectura se visualizará la portada del cuento para realizar predicciones sobre el personaje, los hechos que ocurrirán, etc.
Visionado del vídeo que lo representa.
Lectura del cuento en voz alta con paradas y preguntas para recoger las aportaciones de los niños.
- ¿Quién es Lorenzo?
- ¿Puedes imaginártelo? Su aspecto, su carácter, lo que le gusta y lo que no le gusta…?
- ¿Qué es lo que tiene Lorenzo que no tienen los demás niños?
- ¿Cómo ven las otras personas a Lorenzo cuando va arrastrando el cazo?
- ¿Qué opinan o comentan las otras personas de Lorenzo?
- ¿Cómo se siente Lorenzo? ¿Lo cuenta, lo dice, lo manifiesta?
- ¿Ayuda alguien a Lorenzo?
- ¿Cómo lo hace?
- ¿Qué aprende a hacer Lorenzo con su cazo?
- ¿Cómo se siente al final Lorenzo?
- ¿Qué piensan ahora las otras personas de Lorenzo?
Dibujo alusivo al cuento: la portada o aquella escena que les haya gustado más.
Mural El cazo de Lorenzo
El reino de las bacterias
El Consejo Superior de Investigaciones Científicas (CSIC) y la Fundación Española para la Ciencia y la Tecnología (FECYT) han publicado cuáles son las fotografías ganadoras de la 13ª edición de su certamen Fotciencia, que busca acercar la ciencia y la tecnología a los ciudadanos mediante «una visión artística y estética». El primer premio lo ha ganado esta imagen en la que se puede ver lo que esconde la mano sucia de un niño. La fotografía fue tomada a partir de la huella de una niña de seis años tras posar su mano sobre una placa de Petri, un recipiente utilizado en microbiología para cultivar células. El objetivo era demostrar a alumnos de Infantil y Primaria la importancia que tiene lavarse las manos después, por ejemplo, de jugar con tierra. A través del microscopio se podían apreciar diversas colonias de levaduras y de bacterias.